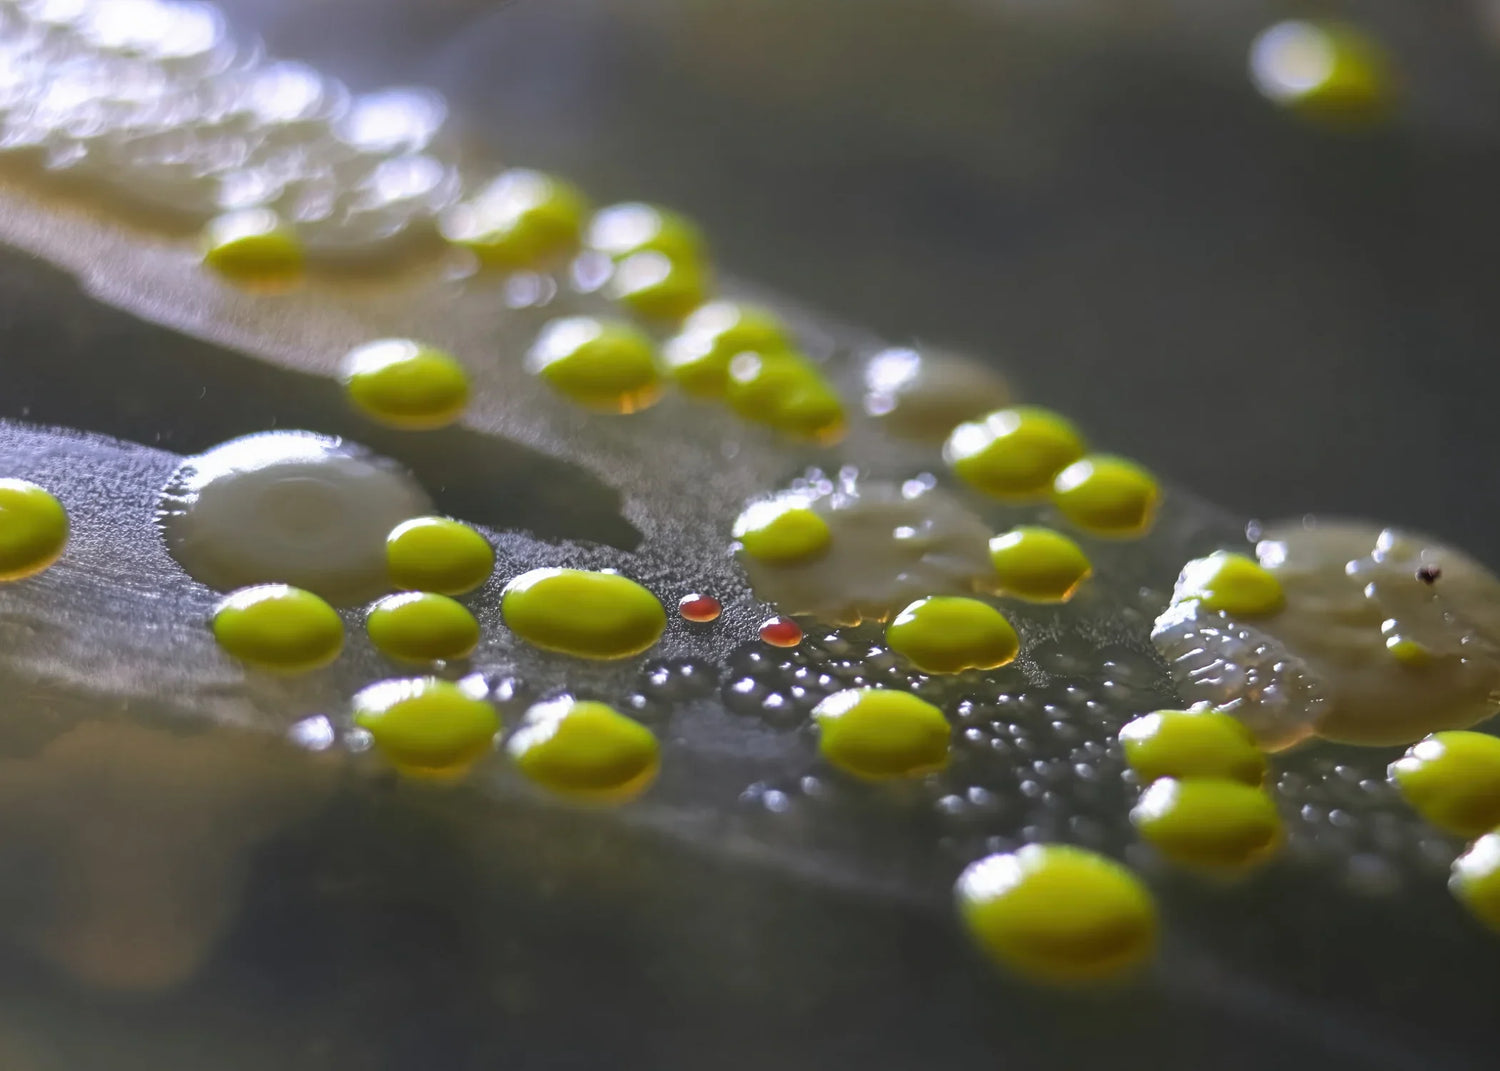
Microscopic view of bacteria growth on a porous surface

Think your living spaces are pristine? You might be surprised to learn that your sofa likely harbors more bacteria than a public toilet seat. Discover how designer couches like the Feathers machine washable sofa are setting a new standard for home hygiene.
You might pride yourself on keeping a clean home, but here's a startling revelation that may make you see your living room in a new light: research suggests that a typical sofa can have more bacteria than a public toilet seat. Yes, you read that right. Your favorite spot to unwind, that plush sectional sofa, could be teeming with more microscopic life forms than a restroom in a busy shopping mall.
Now, consider all the activities that take place on your sofa. Many of us eat meals there, catching up on our favorite TV shows. We nap on it, scroll through social media, work from our laptops, and even entertain guests. Every one of these activities contributes to the buildup of bacteria, dirt, and other contaminants. Your couch might be the centerpiece of your living room, but it's also a focal point for germs if not properly maintained.
The Science of Sofas and Bacteria

To drive home the point, let's look at some numbers. According to a study by UNICEF, sofas can harbor several types of bacteria and may have up to 19,200 germs per 100 cm² compared to 1,600 germs per 100 cm² found on a toilet seat. While these numbers can vary depending on factors like cleaning habits and frequency of use, it's clear that sofas can often be a haven for bacteria.
But what types of bacteria are we talking about? Research shows that sofas can harbor pathogens like Staphylococcus aureus, which can cause skin infections, and even E. coli, known for causing gastrointestinal problems. These aren't just benign bacteria; they can lead to real health issues if not addressed. Particularly concerning is the risk for people with compromised immune systems, for whom these bacteria could lead to serious infections. Given these potential health implications, it becomes increasingly important to consider hygienic solutions when choosing and maintaining your living room furniture.
Factors Contributing to Sofa Bacteria Growth

One of the main reasons why your couch can become a bacterial playground is the nature of upholstery materials. Fabrics like microfiber or traditional cloth are porous, making them excellent traps for dirt, sweat, food particles, and other contaminants. Unlike hard surfaces, these materials have tiny spaces where grime can easily hide, offering bacteria a cozy place to multiply. This is particularly problematic for plush sectional sofas, where the crevices between sections can collect debris, providing even more breeding ground for microbes.
But the material is only part of the equation. Our daily habits significantly contribute to the buildup of bacteria and other germs. Whether it's enjoying a meal while watching TV, taking a quick nap, or allowing pets to lounge with us, these activities deposit additional biological material onto the sofa. Skin cells, oils, and hair from humans and pets can also add to the mix, creating a rich environment for bacterial growth.
Let's also address the elephant in the room: cleaning frequency. Unlike dishes, which we wash daily, or bedsheets, which most people wash weekly, sofas rarely see a cleaning routine. Some may occasionally vacuum their couch or wipe it down with fabric cleaner, but it's generally not enough to maintain a sanitary environment. Compared to other household items, cleaning the couch often falls by the wayside, which only exacerbates the problem of bacterial growth.
The Importance of Sofa Hygiene

When you think about a clean home, you might focus on the kitchen, bathroom, or floors. However, sofa hygiene is an often-overlooked element that is deeply tied to the overall cleanliness of your living space. A bacteria-ridden sofa doesn't just compromise the sanitation of your living room; it can impact the entire household. Family members, including pets, can transfer bacteria from the sofa to other areas of the home. In this way, a dirty sofa becomes more than just a personal issue; it's a public health concern that affects everyone who comes into your home, whether it's a close family member or a guest.
Maintaining a clean sofa isn't just about avoiding the 'ick' factor—it has tangible health benefits. Regularly cleaned upholstery can significantly minimize the presence of allergens such as dust mites and pet dander, which are common triggers for allergies and respiratory issues like asthma. A cleaner sofa can mean fewer sniffles, less frequent allergic reactions, and a generally healthier living environment. In fact, ensuring that the spaces where you spend the most time are clean can even lead to psychological benefits, including reduced stress and increased feelings of well-being. Therefore, maintaining a clean sofa should not be an afterthought; it should be a key component of your holistic approach to a healthy home.
The Game Changer: Feathers Machine Washable Sofa by Mario Capasa

If all this talk about bacteria has you squirming on your sectional, here's the good news: innovation in furniture design has led to game-changing solutions. One such standout product is the Feathers machine washable sofa by Mario Capasa. This designer couch is not just about aesthetics; it's designed with hygiene at its core. Unique features like stain-proof, spill-proof, and scratch-resistant upholstery make it a highly practical choice for modern living. However, the real star feature is its machine washable slipcovers.
What sets the Feathers sofa apart is fully removable covers than you can clean in your washing machine. It’s a revolution in the way we maintain furniture hygiene. Imagine the convenience of simply removing your sofa covers and tossing them into the washing machine. This level of ease dramatically increases the likelihood of regular cleaning, which is the most effective way to keep bacterial growth at bay. And because you can wash the covers yourself, there's no need for harsh chemical cleaners, making it an eco-friendly option as well.
So, how does this help with the bacterial issue? Consistent and regular cleaning is the most effective way to control bacterial growth on any surface, sofas included. The Feathers sofa addresses this by making it easier than ever to maintain a regular cleaning schedule for your upholstery. By taking care of the hotspot for bacteria, you're not just making your couch cleaner; you're making your entire home more sanitary.
Making Hygiene a Priority in Home Furniture Choices

When choosing furniture for your home, it's crucial to consider not just the design and comfort but also the hygiene aspects. In the long run, a sofa that's easy to clean will contribute not only to your health but also to the overall well-being of your household.
This is why innovative solutions like the Feathers machine washable sofa by Mario Capasa stand out. Prioritizing cleanliness and health in your sofa choice doesn't mean you have to compromise on style or comfort. Feathers proves that you can have it all—a designer couch that adds aesthetic value to your home, while also providing an easy and effective way to maintain a sanitary living environment. By choosing furniture that supports your health, you're making a long-term investment in your well-being and the well-being of those you share your home with.
About Valyou Furniture
Valyōu Furniture offers a wide range of designer sofas, including washable sofas, custom couches, and plush sectional sofas. With over 10,000 curated items, we make it easy to create beautiful living spaces that wow your family and friends. Our selection features furniture from acclaimed designers who stay up-to-date with the latest styles, all at fair prices. From design assistance to personalized suggestions, assembly help, and our own delivery service, we're with you every step of the way. Join the Valyōu family and experience a seamless and personal furniture buying process.

Leave a comment
All comments are moderated before being published.
This site is protected by hCaptcha and the hCaptcha Privacy Policy and Terms of Service apply.